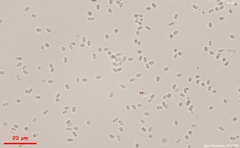
Trichoderma flavipes

Trichoderma flavipes: taxon details and analytics
- Domain
- Kingdom
- Fungi
- Phylum
- Ascomycota
- Class
- Sordariomycetes
- Order
- Hypocreales
- Family
- Hypocreaceae
- Genus
- Trichoderma
- Species
- Trichoderma flavipes
- Scientific Name
- Trichoderma flavipes
Images from inaturalist.org observations:
We recommend you sign up for this excellent, free service.
Parent Taxon
Sibling Taxa
- Hypocrea africana
- Hypocrea armeniacea
- Hypocrea ascoboloides
- Hypocrea aureoviridis
- Hypocrea colensoi
- Hypocrea coprosmae
- Hypocrea egmontensis
- Hypocrea lenta
- Hypocrea macrospora
- Hypocrea manuka
- Hypocrea megalosulphurea
- Hypocrea olivacea
- Hypocrea pilulifera
- Hypocrea scutelliformis
- Hypocrea subcitrina
- Hypocrea subsplendens
- Hypocrea toro
- Microcitrinum
- Podostroma cordyceps
- Podostroma daisenense
- Podostroma eperuae
- Podostroma giganteum
- Podostroma grossum
- Podostroma solmsii
- Trichoderma albofulvum
- Trichoderma alcalifuscescens
- Trichoderma alni
- Trichoderma alutaceum
- Trichoderma americanum
- Trichoderma asperellum
- Trichoderma atrogelatinosum
- Trichoderma atroviride
- Trichoderma aureoviride
- Trichoderma avellaneum
- Trichoderma brevipes
- Trichoderma catoptron
- Trichoderma ceramicum
- Trichoderma cerebriforme
- Trichoderma chlorosporum
- Trichoderma chromospermum
- Trichoderma citrinella
- Trichoderma citrinoviride
- Trichoderma citrinum
- Trichoderma composticola
- Trichoderma cornu-damae
- Trichoderma dacrymycellum
- Trichoderma delicatulum
- Trichoderma deliquescens
- Trichoderma dingleyae
- Trichoderma dorotheae
- Trichoderma estonicum
- Trichoderma flavipes
- Trichoderma foliicola
- Trichoderma fomiticola
- Trichoderma gelatinosum
- Trichoderma hamatum
- Trichoderma harzianum
- Trichoderma hispanicum
- Trichoderma hunua
- Trichoderma koningii
- Trichoderma lacuwombatense
- Trichoderma latizonatum
- Trichoderma leucopus
- Trichoderma lixii
- Trichoderma longibrachiatum
- Trichoderma melanomagnum
- Trichoderma microcitrinum
- Trichoderma minutisporum
- Trichoderma moravicum
- Trichoderma nothescens
- Trichoderma novae-zelandiae
- Trichoderma nybergianum
- Trichoderma orientale
- Trichoderma parareesei
- Trichoderma paraviridescens
- Trichoderma parceramosum
- Trichoderma parmastoi
- Trichoderma patella
- Trichoderma peltatum
- Trichoderma polysporum
- Trichoderma poronioideum
- Trichoderma pseudokoningii
- Trichoderma pulvinatum
- Trichoderma pyrenium
- Trichoderma rogersonii
- Trichoderma semiorbis
- Trichoderma seppoi
- Trichoderma simmonsii
- Trichoderma sinuosum
- Trichoderma spinulosum
- Trichoderma stilbohypoxyli
- Trichoderma strictipile
- Trichoderma sulphureum
- Trichoderma tawa
- Trichoderma victoriense
- Trichoderma vinosum
- Trichoderma viride
- Trichoderma viridescens